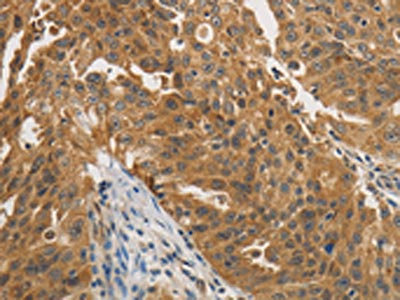

PTPN11 Antibody
-
中文名稱:PTPN11兔多克隆抗體
-
貨號(hào):CSB-PA223710
-
規(guī)格:¥1100
-
圖片:
-
The image on the left is immunohistochemistry of paraffin-embedded Human ovarian cancer tissue using CSB-PA223710(PTPN11 Antibody) at dilution 1/25, on the right is treated with fusion protein. (Original magnification: ×200)
-
The image on the left is immunohistochemistry of paraffin-embedded Human gastric cancer tissue using CSB-PA223710(PTPN11 Antibody) at dilution 1/25, on the right is treated with fusion protein. (Original magnification: ×200)
-
Gel: 10%SDS-PAGE, Lysate: 40 μg, Lane 1-2: NIH/3T3 cells, hela cells, Primary antibody: CSB-PA223710(PTPN11 Antibody) at dilution 1/400, Secondary antibody: Goat anti rabbit IgG at 1/8000 dilution, Exposure time: 1 minute
-
-
其他:
產(chǎn)品詳情
-
Uniprot No.:
-
基因名:
-
別名:BPTP3 antibody; CFC antibody; JMML antibody; METCDS antibody; MGC14433 antibody; NS1 antibody; OTTHUMP00000166107 antibody; OTTHUMP00000166108 antibody; Protein tyrosine phosphatase 2 antibody; Protein tyrosine phosphatase 2C antibody; Protein tyrosine phosphatase non receptor type 11 antibody; Protein-tyrosine phosphatase 1D antibody; Protein-tyrosine phosphatase 2C antibody; PTN11_HUMAN antibody; PTP-1D antibody; PTP-2C antibody; PTP1D antibody; PTP2C antibody; PTPN11 antibody; SAP2 antibody; SH-PTP2 antibody; SH-PTP3 antibody; SH2 domain containing protein tyrosine phosphatase 2 antibody; SHP 2 antibody; SHP-2 antibody; Shp2 antibody; SHPTP2 antibody; SHPTP3 antibody; Syp antibody; Tyrosine-protein phosphatase non-receptor type 11 antibody
-
宿主:Rabbit
-
反應(yīng)種屬:Human,Mouse,Rat
-
免疫原:Fusion protein of Human PTPN11
-
免疫原種屬:Homo sapiens (Human)
-
標(biāo)記方式:Non-conjugated
-
抗體亞型:IgG
-
純化方式:Antigen affinity purification
-
濃度:It differs from different batches. Please contact us to confirm it.
-
保存緩沖液:-20°C, pH7.4 PBS, 0.05% NaN3, 40% Glycerol
-
產(chǎn)品提供形式:Liquid
-
應(yīng)用范圍:ELISA,WB,IHC
-
推薦稀釋比:
Application Recommended Dilution ELISA 1:1000-1:2000 WB 1:200-1:1000 IHC 1:25-1:100 -
Protocols:
-
儲(chǔ)存條件:Upon receipt, store at -20°C or -80°C. Avoid repeated freeze.
-
貨期:Basically, we can dispatch the products out in 1-3 working days after receiving your orders. Delivery time maybe differs from different purchasing way or location, please kindly consult your local distributors for specific delivery time.
-
用途:For Research Use Only. Not for use in diagnostic or therapeutic procedures.
相關(guān)產(chǎn)品
靶點(diǎn)詳情
-
功能:Acts downstream of various receptor and cytoplasmic protein tyrosine kinases to participate in the signal transduction from the cell surface to the nucleus. Positively regulates MAPK signal transduction pathway. Dephosphorylates GAB1, ARHGAP35 and EGFR. Dephosphorylates ROCK2 at 'Tyr-722' resulting in stimulation of its RhoA binding activity. Dephosphorylates CDC73. Dephosphorylates SOX9 on tyrosine residues, leading to inactivate SOX9 and promote ossification.
-
基因功能參考文獻(xiàn):
- Genetic or pharmacologic inactivation of SHP2 promotes accumulation of JAK2 phosphorylated at Y570, reduces JAK2/STAT3 signaling, inhibits TGFbeta-induced fibroblast activation and ameliorates dermal and pulmonary fibrosis. PMID: 30108215
- Authors identify that miR-186 serves as a tumor suppressor in OSCC. Downregulation of this microRNA may lead to a higher expression of oncogenic factor SHP2, which leads to activation of growth promoting signaling. PMID: 29407635
- REVIEW: structural basis and recent research progression on SHP2 in various human disease, including genetic and cancer diseases. PMID: 27028808
- the tumor promoting role of YAP is involved in SHP2 which functions as a tumor promoter in vitro but as a tumor suppressor in vivo PMID: 29699904
- Data indicate that by inhibiting adenine nucleotide translocase 1 (ANT1) and mitochondrial dysfunction, tyrosine phosphatase SHP2 orchestrates an intrinsic regulatory loop to limit excessive NLR family, pyrin domain-containing 3 protein (NLRP3) inflammasome activation. PMID: 29255148
- Findings revealed that SHP2 is associated with cisplatin-induced drug resistance in lung cancer and directly activates Ras, which in turn regulates the PI3K/Akt pathway. PMID: 29207183
- SHP-2 is activated by CD16b crosslinking in neutrophils. PMID: 29137913
- Proliferation and soft agar assays were used to demonstrate the functional contribution of SHP2 to cell growth and transformation. SHP2 expression correlated with SOX2 expression in glioma stem cell (GSC) lines and was decreased in differentiated cells. Forced differentiation of GSCs by removal of growth factors, as confirmed by loss of SOX2 expression, also resulted in decreased SHP2 expression. PMID: 28852935
- PTPN11 plays a role in regulating neurotrophin protective signaling in neuronal cells; PTPN11 dysregulation promotes apoptotic activation. PMID: 28947394
- This study provides information on phenotypes observed in Noonan syndrome patients with different PTPN11 mutations and defines two novel mutations. PMID: 26817465
- SHP-2 protein may become a new target for anti-malignant transformation of glioma. PMID: 28620155
- High SHP2 expression is associated with colorectal tumors. PMID: 27582544
- SHP2 expression was activated by the HBx-NF-kappaB pathway. In patients with HCC, a loss of SHP2 expression was associated with suppressed NF-kappaB-SHP2-ERK pathway activity and accelerated HCC development, whereas SHP2 overexpression in parallel with increased STAT3 activity was associated with fibrosis promotion during the early stages of HCC development. PMID: 28460481
- The inhibitory action of cryptotanshinone is largely attributed to the inhibition of STAT3 Tyr705 phosphorylation with a novel mechanism of upregulating the tyrosine phosphatase activity of SHP-2 protein. PMID: 28492557
- Studies indicate that multiple classes of PTPN11 mutations with a distinct perturbing effect on SHP2's function. PMID: 28074573
- Mutational status of NRAS, KRAS, and PTPN11 genes is associated with genetic/cytogenetic features in children with B-precursor acute lymphoblastic leukemia. PMID: 28853218
- Studied mutations of PTPN11 in a cohort of Noonan Syndrome patients. Mutational analysis was performed and PTPN11 mutations were detected in 11 out of 17 (64.7%) patients with Noonan syndrome; 72% had mutation in exon 3 and 27 % had mutation in exon 13. PMID: 28607217
- NO controls the calcium signal propagation through Cx37-containing gap junctions. The tyrosine phosphatase SHP-2 is the essential mediator and NO target. PMID: 29025706
- we describe patients with craniosynostosis and Noonan syndrome due to de novo mutations in PTPN11 and patients with craniosynostosis and CFC syndrome due to de novo mutations in BRAF or KRAS. All of these patients had cranial deformities in addition to the typical phenotypes of CFC syndrome and Noonan syndrome. PMID: 28650561
- These results suggest that SHP-2-via association with ICAM-1-mediates ICAM-1-induced Src activation and modulates VE-cadherin switching association with ICAM-1 or actin, thereby negatively regulating neutrophil adhesion to endothelial cells and enhancing their transendothelial migration. PMID: 28701303
- High PTPN11 expression is associated with suppression of T lymphocyte function in Melanoma. PMID: 27930879
- PTPN11 mutations are the most common cause of the Noonan syndrome, along with frequent neuroepithelial brain tumors. (Review) PMID: 28328117
- A novel PTPN11 mutation defined in two separate fetuses with Cystic hygroma and associated with Noonan syndrome phenotype is being reported. PMID: 27193571
- High PTPN11 expression is associated with Pancreatic cancer. PMID: 27213290
- SHP-2 acts together with PI3K/AKT to regulate a ZEB1-miR-200 feedback loop in PDGFRalpha-driven gliomas. PMID: 27041571
- The data presented in the current study reveal that intestinal serotonin transporter (SERT) is a target of the tyrosine phosphatase SHP2 and show a novel mechanism by which a common diarrheagenic pathogen, EPEC, activates cellular SHP2 to inhibit SERT function. PMID: 28209599
- The effects of SHP2 overexpression and inhibition on fibroblast response to profibrotic stimuli were analyzed in in primary human fibroblasts. SHP2 was down-regulated and lung fibroblasts obtained from patients with IPF, revealing SHP2 was absent within fibroblastic foci sufficient to induce fibroblast-to-myofibroblast differentiation in primary human lung fibroblasts, resulting in reduced cell survival. PMID: 27736153
- PTPN11 variant was identified in a case with a lethal presentation of Noonan syndrome. PMID: 28098151
- Appropriate knowledge of the phenotype-genotype correlations and of the outcome of cochlear implantation in genetic hearing impairment is important in the work-up to a CI PMID: 28483241
- our results provide strong evidence that CD244 co-operates with c-Kit to regulate leukemogenesis through SHP-2/p27 signaling. PMID: 28126968
- SHP2, SOCS3 and PIAS3 levels are reduced in medulloblastomas in vivo and in vitro, of which PIAS3 downregulation is more reversely correlated with STAT3 activation. In resveratrol-suppressed medulloblastoma cells with STAT3 downregulation and decreased incidence of STAT3 nuclear translocation, PIAS3 is upregulated, the SHP2 level remains unchanged and SOCS3 is downregulated. PMID: 28035977
- could promote hepatocellular carcinoma cell dedifferentiation and liver cancer stem cell expansion by amplifying beta-catenin signaling PMID: 28059452
- The results revealed that although the expression levels of SOCS1, SOCS3 and, in particular, pSHP2, tend to decrease in the four types of astrocytomas, PIAS3 downregulation is more negatively correlated with STAT3 activation in the stepwise progress of astrocytomas and would indicate an unfavorable outcome. PMID: 28035384
- In a retroviral transduction/transplantation mouse model, mice transplanted with MLL/AF10(OM-LZ) cells harboring PTPN11(wt) developed myelomonocytic leukemia. Those transplanted with cells harboring PTPN11(G503A) -induced monocytic leukemia in a shorter latency. Adding PTPN11(G503A) to MLL/AF10 affected cell proliferation, chemo-resistance, differentiation, in vivo BM recruitment/clonal expansion and faster progression. PMID: 27859216
- Shp2 (Src-homology 2 domain-containing phosphatase 2) functions as a negative regulator for STAT3 transcription factor (Stat3) activation in esophageal squamous cell cancer (ESCC). PMID: 28085101
- the phosphatase activity of Shp2 and its tyrosine phosphorylation, are necessary for the IL-6-induced downregulation of E-cadherin and the phosphorylation of Erk1/2. Our findings uncover an important function that links Shp2 to IL-6-promoted breast cancer progression. PMID: 28208810
- This study reveals the critical contribution of Ptpn11 mutations in the bone marrow microenvironment to leukaemogenesis and identifies CCL3 as a potential therapeutic target for controlling leukaemic progression in Noonan syndrome and for improving stem cell transplantation therapy in Noonan-syndrome-associated leukaemias. PMID: 27783593
- higher expression of SHP2 might be involved in the progression of pancreatic ductal adenocarcinoma, suggesting that SHP2 may be a potential prognostic marker and target for therapy PMID: 26695153
- Data indicate that the most prominent proteins associating with Gab2 are PTPN11, PIK3R1 and ARID3B. PMID: 27025927
- Since rs2301756 polymorphism of PTPN11 was associated with reduced risk of gastric cancer and better effects of chemotherapy on gastric cancer, it can be considered as a predictor of gastric cancer prognosis and the treatment target for gastric cancer. PMID: 27614952
- SHP2 gain-of-function mutation enhances malignancy of breast carcinoma. PMID: 26673822
- mutation in PTPN11 is associated with co-occurrence of hypertrophic cardiomyopathy and myeloproliferative disorder in a neonate with Noonan syndrome. PMID: 26286251
- The existence of a tight association between SHP2 and EGFR expression in tumors and cell lines further suggested the importance of SHP2 in EGFR expression. PMID: 26728598
- patients with low Shp2 expression exhibited superior prognosis to sorafenib PMID: 25865556
- Combined X-ray crystallography, small-angle X-ray scattering, and biochemistry to elucidate structural and mechanistic features of three cancer-associated SHP2 variants with single point mutations within the N-SH2:PTP interdomain autoinhibitory interface. PMID: 27030275
- In vitro assays suggested that LEOPARD syndrome-associated SHP-2 mutations might enhance melanin synthesis in melanocytes, and that the activation of Akt/mTOR signalling may contribute to this process. PMID: 25917897
- SHP2 may promote invadopodia formation through inhibition of Rho signaling in cancer cells. PMID: 26204488
- Shp2 promotes metastasis of prostate cancer by attenuating the PAR3/PAR6/aPKC polarity protein complex and enhancing epithelial-to-mesenchymal transition PMID: 26050620
- PTPN11 is a central node in intrinsic and acquired resistance to targeted cancer drugs. PMID: 26365186
- SHP2 preferentially binds to and dephosphorylates Ras to increase its association with Raf and activate downstream proliferative Ras/ERK/MAPK signaling. PMID: 26617336
顯示更多
收起更多
-
相關(guān)疾?。?/div>LEOPARD syndrome 1 (LPRD1); Noonan syndrome 1 (NS1); Leukemia, juvenile myelomonocytic (JMML); Metachondromatosis (MC)亞細(xì)胞定位:Cytoplasm. Nucleus.蛋白家族:Protein-tyrosine phosphatase family, Non-receptor class 2 subfamily組織特異性:Widely expressed, with highest levels in heart, brain, and skeletal muscle.數(shù)據(jù)庫鏈接:
Most popular with customers
-
-
Phospho-YAP1 (S127) Recombinant Monoclonal Antibody
Applications: ELISA, WB, IHC
Species Reactivity: Human
-
-
-
-
-
-